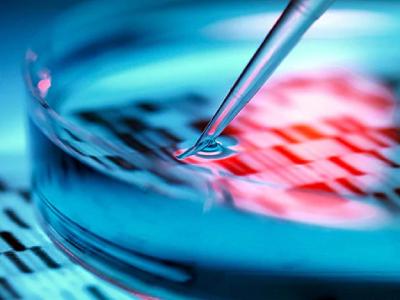

एक ‘असा’ बैल तयार, ज्याची पुढील सर्व पिढी नर म्हणून जन्माला येणार; वैज्ञानिकांचा दावा
By ऑनलाइन लोकमत | Updated: July 27, 2020 11:46 IST2020-07-27T11:42:32+5:302020-07-27T11:46:21+5:30

वैज्ञानिकांनी असा एक बैल तयार केला आहे ज्याच्या पुढील पिढ्यांमध्ये बहुतांश नर असतील. या बैलाच्या जीन्समध्ये सुधारणा करण्यात आली आहे. असं करण्यामागील कारण म्हणजे फूड इंडस्ट्रीमध्ये नर बैलांना जास्त मागणी आहे.

कॉस्मो (COSMO) असं या बैलाचं नाव आहे. कॅलिफोर्निया विद्यापीठातील डेव्हिस या शास्त्रज्ञांनी हा तयार केला आहे. त्याच्या जीन्समध्ये असे बदल केले गेले आहेत, ज्यामुळे याची वासरे जन्माला येतील ते नर असतील.

मांस उद्योगात नर बैलांना जास्त मागणी आहे. कारण त्यांचे वजन अधिक आहे. ते गायींपेक्षा १५ टक्के जास्त वजन देतात. तर दुग्धजन्य पदार्थांसाठी गायींचा वापर केला जातो.

कॉस्मो (COSMO) गायींच्या अशा प्रजातीमधून विकसित केलेला नर वासरू आहे, जो दुधासाठी नव्हे तर मांसासाठी ओळखला जातो. गायींच्या या प्रजातीच्या मांसाला जगभर मागणी आहे.

कॅलिफोर्निया विद्यापीठातील शास्त्रज्ञांनी एप्रिल महिन्यात कॉस्मो (COSMO) ला जन्म दिला. जेव्हा त्याचा जन्म झाला तेव्हा त्याचे वजन 110 पौंड होते म्हणजेच सुमारे 50 किलोग्राम. हे वजन निरोगी नर वासरासाठी योग्य मानले जाते.

काळ्या रंगाचा कॉस्मो (COSMO) च्या जीन्समध्ये बदल करुन यात क्रोमोसोम -17 मध्ये एसआरवाय जीन घालून सुधारित केले आहेत. त्याच्या जनुकांमुळे, कॉस्मो (COSMO) भविष्यात केवळ नर वासरे तयार करण्यात मदत करेल.

एसआरवाय जनुक नर विकासास प्रोत्साहन देते. या जीनसह जगणे, जीवात कोणत्या गुणसूत्रांमध्ये प्रभावी आहे याचा फरक पडत नाही. XY गुणसूत्र सहसा नर जीव तयार करतात. तर, एक्सएक्सएक्स मादी जीव. परंतु एसआरवाय जनुक टाकल्यानंतर एक्सएक्सएक्स गुणसूत्र कमकुवत होते आणि पुरुष गुणसूत्र प्रबल होते

कॅलिफोर्निया विद्यापीठाच्या अॅनिमल जनुकशास्त्रज्ञ एलिसन वॅल एनेनम यांनी सांगितले की, कॉस्मोच्या पुढील पिढ्या नर जन्माला येतील. तो कोणत्याही मादीशी संबंध बनवतो याचा फरक पडणार नाही किंवा त्या मादीचे गुणसूत्र किती प्रभावी आहेत याचाही फरक नाही.

एलिसन म्हणाले की आम्ही सीआरआयएसपीआर तंत्राने कॉस्मो (COSMO) चे जीन सुधारित केले आहेत. त्याचा फायदा आम्हाला त्याची संपूर्ण जीन्स बदलण्याची गरज नव्हती. आम्ही नुकतेच एसआरवाय जीन टाकल्याने काम झाले.

कॉस्मो (COSMO) सध्या खूपच लहान आहे. या क्षणी आम्ही त्याच्या अन्नाची पूर्ण काळजी घेत आहोत. त्याला खूप खेळायला द्या जेणेकरून त्याची चपळता अखंड राहील. 12 महिन्यांनंतर आम्ही त्याला एका मादीबरोबर वेळ घालवू देऊ, जेणेकरुन आमच्या प्रयोगाचा निकाल आम्हाला दिसू शकेल.
यामुळे जन्मलेली पुढची पिढी नर जन्माला आली तर आपला प्रयोग यशस्वी होईल. कारण त्याचे जीन्स एसआरवाय जीनमध्ये देखील प्रभावी ठरतील, जे नंतर आपल्याला केवळ नर बैलांना देईल. आम्ही असे गृहीत धरत आहोत की 75 टक्के नर आणि 25% मादी जन्माला येतील.

















